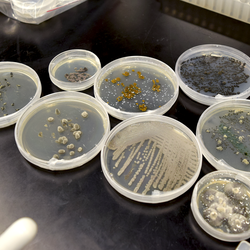
plpa-mcbl-blank-profile

(M.S. & PhD)
Contacts
Director and Graduate Advisor for Admissions
Graduate Advisor for Continuing Students
Graduate Student Services Advisor
Plant Pathology Graduate Program
(M.S. & PhD)
Contacts
Graduate Advisor for Continuing Students
Graduate Advisor for Admissions
Graduate Student Services Advisor
Microbiology Undergraduate Major
(B.S.)
Contacts
Lead Faculty Advisor, Microbiology Undergraduate Major
Microbiology Academic Advisor